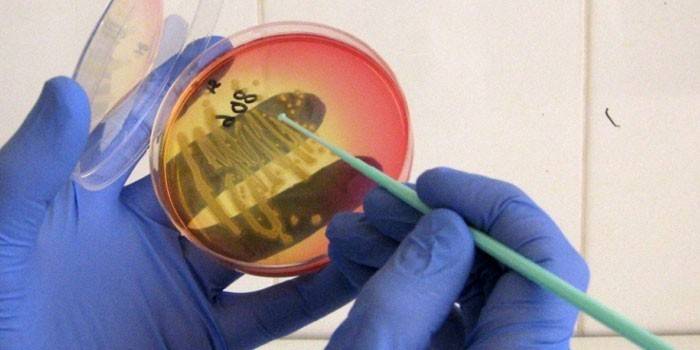

Kožná kandidóza - príčiny, príznaky, diagnostika, lokalizácia v tele a liečebné metódy
Podľa lekárskych údajov sa u ľudí rôzneho veku neustále zvyšuje patológia plesní. Kožná kandidóza je infekčné ochorenie vyvolané Candidou, ktoré sa často tvorí na záhyboch, ale môže mať vplyv aj na hladkú pokožku tela, napríklad u dieťaťa, ktoré sa vyvíja na zadku v perineu. Nemali by ste ignorovať prejavy patológie, včasná liečba pomôže skrátiť trvanie liečby a zlepšiť prognózu.
Čo je kožná kandidóza
Táto patológia je spôsobená patogénom rodu Candida, na povrchu dermy alebo sliznice sa vyvíjajú klinické príznaky. Kožná kandidóza sa často prejavuje na miestach, kde sa vytvára vlhké prostredie (kožné záhyby), čo pomáha huby aktívne sa rozvíjať. V ľudskom tele je vždy prítomná v malej koncentrácii, ich reprodukcia je aktivovaná v nepriaznivých podmienkach pre pacienta. Vývoj choroby často naznačuje porušenie imunitného systému alebo prítomnosť iného ochorenia, ktoré bolo impulzom pre ochorenie kože.
Príčiny výskytu
Mykóza (plesňová infekcia) sa vyskytuje s aktivitou patogénnych mikroorganizmov, ktoré sú mnohými v životnom prostredí% na zelenine a ovocí, v pôde atď. Geek môže parazitovať na koži zvierat alebo ľudí, takže pri kontakte s nosičom môže dôjsť k infekcii. Stále existujú podmienečne patogénne alebo nepatogénne druhy húb, ktoré sú v ľudskom tele normou a vyvolávajú chorobu iba za nepriaznivých podmienok.
Drozd na koži sa môže objaviť aj u novorodencov, pretože od prvého dňa života prenikajú do ľudského tela. Toto je norma a nepredstavuje hrozbu, ak ich provokujúce faktory neprekladajú do patogénneho stavu. Príčiny, ktoré spôsobujú kandidózu, rozdeľujú na dve skupiny: internú a externú.Medzi prvé patria provokatívne procesy, ktoré sa vyskytujú vo vnútri tela. Všetky spravidla vedú k oslabeniu imunity, napríklad:
- diabetes mellitus a ďalšie endokrinné patológie;
- choroby gastrointestinálneho traktu;
- závažná chirurgia a pooperačná terapia;
- intoxikácia (droga, alkohol);
- onkologické patológie, leukémia s chemoterapiou;
- nedostatok vitamínu;
- imunosupresívna terapia;
- dlhodobé používanie antibiotík;
- AIDS.

Medzi vonkajšie faktory patria faktory, ktoré ovplyvňujú životné prostredie. Tieto zahŕňajú:
- Nesprávny výber oblečenia. To vedie k narušeniu prenosu tepla, zvýšenému poteniu, ktoré vytvára vlhké a teplé prostredie, ktoré je ideálne pre množenie huby a prechod do patogénneho stavu.
- Výrobné riziká. Táto skupina zahŕňa možný kontakt hladkej pokožky alebo slizníc s zásadami, kyselinami.
- Vredy, trhliny, mikrotrauma. Nesprávna manikúra, popraskanie kože, odieranie atď. Ich môže vyprovokovať.
- Nedostatočná hygiena.
príznaky
Kandidóza sa môže objaviť na tvári, na zadku (u dieťaťa), na slizniciach genitálií alebo v ústach, na miestach, kde pokožka vytvára prirodzené záhyby. Existuje mnoho typov tejto patológie, každá z nich má určité špecifické príznaky, ale niektoré príznaky sú spoločné pre všetky formy. Ochorenie môže mať nasledujúce príznaky:
- vločky na koži;
- vyrážka;
- červené, fialové škvrny;
- v postihnutých oblastiach pociťuje svrbenie;
- na slizniciach sa často tvoria biele škvrny;
- objavujú sa praskliny a bolesť;
- macerácia pokožky - pri nadmernej vlhkosti dochádza k opuchom;
- erytém;
- na okrajoch postihnutých oblastí sa tvoria pustuly;
- v ústach sa tvoria červené, biele lézie.
Kandidóza kože u detí
U 20% novorodencov sa táto patológia vyskytuje. V niektorých prípadoch sa huby Candida dostanú k dieťaťu vo fáze vnútromaternicového vývoja, dieťa môže nakaziť v nemocnici, pôrodnici alebo pri prechode pôrodom cez genitálny trakt. Plienka a kandidóza veľkých záhybov (intertrigo) sa zvyčajne diagnostikujú kvôli štrukturálnym vlastnostiam dermy v tomto veku. Pokožka je voľnejšia, vrstvy sú menšie, tajná a mechanická ochrana dieťaťa je stále nedokonalá.
Symptomatické príznaky sa často vyvíjajú na zadku, vnútornom stehne a perineu. Z príznakov sa rozlišujú nasledujúce prejavy:
- plač, začervenanie a opuch v mieste poškodenia kožných húb;
- okolo svrbivého miesta sa objaví koruna exfoliačnej epidermy;
- dieťa sa neisto chová, tento stav sa zintenzívňuje pri zmene plienky, stolice a močenia.
klasifikácia
Kandidomykózu kože možno určiť podľa výskytu papúl, vezikúl, ktoré sa zlúčia do jedného miesta a otvoria sa. Postihnutý povrch sa sfarbí na červeno a belavo, stáva sa hladkým, lesklým a vlhkým. Existuje určitá klasifikácia kandidózy, ktorá sa líši príznakmi, miestom vývoja. Hlavnými formami patológie sú:
- Intertrigo alebo kandidóza veľkých záhybov kože. Sú to zvyčajne postihnuté oblasti v podpazuší, dolná časť mliečnych žliaz (hrudník), interglutealný záhyb (častejšie u detí a starších ľudí s nadmerným viscerálnym tukom), v oblasti trieslovín-femor. V týchto miestach sa tvoria hnedé, červené škvrny, na okrajoch sa odlupuje pokožka, je prítomný belavý povlak. Toto je sprevádzané bolesťou, pálením a svrbením.
- Mykotický džem. V rohoch úst sa objaví belavý povlak, ak je zoškrabaný, pod ním bude začervenanie.U starších ľudí sa častejšie diagnostikuje, ak dôjde k maloklúzii. Ďalšou príčinou záchvatov je neustále zvlhčenie týchto oblastí slinami (macerácia) alebo nesprávna veľkosť chrupu, ktorá spôsobuje nadmerné slinenie.
- Kandidóza červeného okraja pier. Táto forma sa často kombinuje s predchádzajúcou, k vyššie uvedeným príznakom sa pridáva tvorba šupín, hlboké praskliny na spodnej pery, ktoré sú navyše sprevádzané edémom.
- Kandidózia stomatitída. Pri tejto forme patológie ovplyvňuje infekcia bočné povrchy úst, jazyka, tvaru zúžených bielych škvŕn, ktoré sú veľmi bolestivé. Stomatitída naznačuje silné zníženie imunitnej obrany, ktoré sa často vyskytuje u detí.
- Interdigitálna kandidóza. Bežnejšie u žien sa medzi prstencom a prostrednými prstami objavujú červené škvrny. Je to kvôli častému a dlhotrvajúcemu kontaktu s vodou, čistiacimi prostriedkami (čistiace prostriedky, práčovne, ženy v domácnosti). Medzi prstami sa môžu objaviť škvrny, jedná sa však o veľmi zriedkavý jav.
- Kvasinková paronychia. Poškodenie periunguálnych hrebeňov nastáva, napučiavajú a pri stlačení z nich vyteká malé množstvo hnisu.
- Kandidóza dlaní. Táto forma sa stáva dôsledkom vyššie uvedených dvoch typov, objavujú sa bubliny, ktoré sa potom odlupujú. V niektorých prípadoch je zaznamenané zhrubnutie kože dlaní.
- Kandidóza chodidiel. Častejšie sa diagnostikuje u detí, vytvárajú sa bubliny, pľuzgiere a šupinaté škvrny.
- Genitálna kandidóza. U mužov sa táto forma nazýva rovnováha a u žien vulvitída. Vyznačuje sa výskytom povrchových vezikúl, vyrážok, belavých škvŕn, prasklín. Patológia je spravidla sprevádzaná pálením, svrbením. Na penise žaluďov sa môže objaviť výtok. Niekedy môže byť choroba asymptomatická po dlhú dobu alebo s veľmi miernymi príznakmi.
- Zápal folikulitídy. Lokalizácia infekcie je vo vlasových folikuloch, podpazušiach, u mužov na tvári (fúzy, brady), zriedka postihuje pokožku hlavy.
- Kandidóza tváre a hladká pokožka. Vzácna forma choroby, infekcia sa vyskytuje cez pokožku tváre, oboch z nosa, bližšie k ušiam a krku. V mieste lézie sa vyvíjajú klasické príznaky choroby. Často diagnostikovaná choroba u detí.
- Kandidóza bradaviek. Vyvíja sa spravidla u dojčiacich matiek. Okolo bradavky sa vytvorí belavý povlak a šupiny, môžu sa objaviť praskliny.
diagnostika
Väčšina dermatológov môže podozrenie na plesňovú infekciu jednoducho vizuálnou kontrolou, ale pred začatím liečby je na potvrdenie odhadu potrebné množstvo diagnostických testov. Na tieto účely môže lekár predpísať tieto testy:
- škrabanie kože na vyšetrenie pod mikroskopom, ktoré odhaľuje prvky mycélia, oválne bunky huby;
- analýza kožných zmien;
- výsevom atypického biomateriálu na síru Saburo za účelom rozpoznania typu patogénu sa hodnotí jeho odpoveď na antimykotiká;
- PCR diagnostika kandidózy;
- enzýmový imunotest;
- imunofluorescenčná reakcia;
- imunogram, krvný glukózový test a krvný test.
Liečba kandidózy kože
Pre úspešnú liečbu patológie je potrebné použiť integrovaný prístup. Kandidóza na tele je prejavom oslabenej imunity, aktivácie huby vo vnútri tela, takže na liečbu sa používajú tieto pokyny:
- Boj proti patogénu. Na tieto účely sa používajú antimykotiká, antiseptiká, ktoré sa dajú kúpiť v lekárni vo forme mastí, krémov, pást a alkoholových tinktúr.
- Zničenie endogénneho zdroja patogénu v genitourinárnom systéme a gastrointestinálnom trakte. Liečba sa vykonáva pomocou systémových liekov, ktoré sa užívajú perorálne, čapíkov alebo douchingov.
- Liečba sprievodných chorôb, ktoré vyvolali aktiváciu kandidózy.
- Posilňujúce opatrenia na posilnenie imunitnej obrany: prijímanie vitamínov (PP, K2, B6, B2), diéta, zdravý životný štýl.
- Vylúčenie vonkajších dráždivých látok, používanie rukavíc, hygienické opatrenia.
Systémové lieky
Tento smer sa používa spolu s lokálnou terapiou. Ak sa choroba rýchlo šíri, je dôležité začať včas čerpať prostriedky. Je dovolené užívať tablety alebo injekcie. Najúčinnejšie systémové lieky sú tieto lieky:
- Flukonazol. K dispozícii vo forme injekčného roztoku, sirupu a kapsúl (známy ako Flumikon, Diflucan, Flucostat, Mikosist). Dávka pre dospelého je 100 - 200 mg, denná dávka pre deti sa počíta v závislosti od hmotnosti (na 1 kg je potrebné 5 mg látky). Kurz trvá od 1 do 2 týždňov.
- Itrakonazol (aka Rumikoz, Irunin, Orungal). Pre dospelých dávka 100 mg 2-krát denne alebo 200 mg jedenkrát. Priebeh liečby liekom je 1 - 2 týždne bez prestávky alebo 2 - 3 mesiace podľa prerušovanej schémy: po 7 dňoch je prestávka 20 dní.
- Ketokonazol užívajú dospelí v dávke 200 mg denne.
- Lekár môže predpísať antibiotickú liečbu z polyénovej série Pimafucín. Dávka pre dospelých je 100 mg 4-krát denne. Deti môžu dostať takéto lieky iba striktne po odporúčaní pediatrom. Dávka: 50 mg až 4-krát denne. Liečba týmto liekom trvá 2 až 4 týždne.
- Nystatín. Kurz je predpísaný od 2 do 4 týždňov, dospelí užívajú 10 000 00 IU trikrát denne. Pred opakovaním liečby je potrebné prerušiť najmenej 2 týždne.

Protiplesňové masti
Akékoľvek lieky v tejto skupine by sa mali vyberať individuálne pre každého pacienta. Lokálne liečivá sa predpisujú v závislosti od typu patogénu, pretože všetky liečivá sa líšia v liečivej látke, ktorá je účinná proti konkrétnemu typu huby. Z moderných možností si môžete vybrať nasledujúce možnosti pre masti, krémy:
- Sebozol. Vyrába sa vo forme masti, krému, liečivo je ketokonazol. Má fungistatický a fungicídny účinok. Odoláva patogénom kandidózy, viacfarebným lišajníkom, systémovým mykózam. Ľudia, ktorí sú precitlivení na ketokonazol, môžu po aplikácii pociťovať podráždenie pokožky. V takýchto prípadoch je lepšie prestať používať masť a zvoliť si iný liek.
- Ekzoderil. Jedná sa o švajčiarsky liek, ktorý pomáha v boji proti širokému spektru húb a ich spór. Na liečenie kandidózy je vhodnejšia krémová dávková forma. Liek preniká dobre do vrstiev dermy, dosahuje potrebnú koncentráciu, aby zabezpečil protiplesňový účinok. Krém sa môže aplikovať na hladkú pokožku tela, kde sa lézia vyvinula, ale predtým by sa mala dobre umyť a vysušiť. Podľa pokynov sa odporúča namazať pokožku a okolo ohniska peelingu a zápalu. Priebeh liečby Exoderilom trvá 2-4 týždne, po zjavnom vymiznutí kandidózy sa odporúča pokračovať v užívaní lieku ďalších 14.
- Mikospor. Tento protiplesňový krém má široké spektrum účinku. Bolo preukázané, že je účinný proti dermatofytom, plesniam podobným kvasinkám, patogénom seborrhea, plesniam a erytrazme. Jedna dávka na aplikáciu na pokožku s plochou 10 metrov štvorcových. cm je 1 cm znamená. Namažte postihnutú oblasť 1 krát denne pred spaním. Priebeh liečby je 2 až 4 týždne, tento ukazovateľ sa môže líšiť v závislosti od typu patogénu. Lieky sa považujú za bezpečné, ale pred liečbou tehotných žien a detí je potrebné poradiť sa s lekárom.
- Nizoral. Hlavnou účinnou látkou je ketokonazol. Protiplesňový krém je účinný proti väčšine infekcií kože, nechtov alebo slizníc. Spôsob použitia závisí od typu patogénu.Aplikácia sa spravidla vykonáva 2-krát denne na lézii a zachytí malú plochu vedľa nej. Je ukázaný liek na liečenie rôznych dermatofytických infekcií, seboroickej dermatitídy, kandidózy kože, epidermofytózy a versicolor. Liečba trvá 2 až 4 týždne, potom musíte sledovať udržiavaciu liečbu ďalších 14 dní.
Význam diéty pre kandidózu kože
Osoba v tele má vždy huby rodu Candida, ktoré sú na pokožke, slizniciach. Nezvolávajú vývoj chorôb a neprechádzajú do patogénnej formy, len keď je imunita oslabená. Významný vplyv na pravdepodobnosť rozvoja kandidózy má stav črevnej mikroflóry. Z tohto dôvodu je dôležité dodržiavať pravidlá zdravej výživy, aby sa minimalizovala pravdepodobnosť vzniku choroby alebo aby sa urýchlilo jej zotavenie. Pri riziku vzniku kandidózy sa odporúča:
- výrazne znížiť spotrebu vysoko sacharidových a sladkých potravín, úplne opustiť rýchle občerstvenie, ktoré obsahuje transgénne tuky;
- Pre vaše menu nepoužívajte polotovary;
- zvýšiť počet potravín obsahujúcich vitamíny, vlákninu;
- v menu by mali byť kyslé mliečne výrobky: kefír, nesladený jogurt;
- odmietnuť vyprážané mäso, na varenie je lepšie použiť dvojitý kotol, môžete piecť mäso;
- jesť viac červenej papriky, propolisu, cesnaku a cibule (protiplesňové potraviny);
- znížiť spotrebu alkoholu, majonézy, horčice, sójovej omáčky, mlieka, kečupu, sladkých jedál (vrátane medu).
Ľudové metódy
Pri komplexnej liečbe ochorenia môžu byť domáce lekárske predpisy zahrnuté do liečebného režimu po konzultácii s lekárom. Niektoré byliny majú nevyhnutný liečivý, posilňujúci imunitný účinok, pomáhajú zmierniť opuch slizníc, svrbenie, majú protizápalové a baktericídne účinky. Na rôzne spôsoby spravidla používajú nechtík, strunu, harmanček, borievku, ľubovník bodkovaný a ďalšie. Môžete použiť nasledujúce recepty:
- Na prípravu liekovej infúzie je potrebné užiť 3 lyžice. l. harmanček alebo ľubovník bodkovaný, nalejte 1 liter vriacej vody a nechajte ho uvariť 3 hodiny. Potom je potrebné produkt preťať cez gáč a vložiť ho dovnútra, môžete ho aplikovať na obväz a aplikovať ho vo forme obkladov pred spaním na postihnuté miesta.
- Rozdrvte a zmiešajte lístky mäty so soľou. Táto zmes sa aplikuje na miesto zápalu 1 hodinu.
- Vezmite 1 šálku pohánky, vložte ju do vriacej vody (3 šálky) a varte 10 minút. Vypustite vývar a nechajte ho vychladnúť. Utrite postihnuté miesto 2-3 krát denne.

prevencia
Kandidóza hladkej pokožky je zriedka počiatočné a jediné ochorenie. Spravidla sa prejavuje vo vývoji inej patológie, ktorá znižuje imunitnú obranu tela. Z tohto dôvodu je potrebné usmerňovať preventívne opatrenia na zachovanie imunity, prevenciu dysbiózy a prevenciu akýchkoľvek infekčných patológií. Medzi hlavné body, ktoré bránia rozvoju choroby, patria tieto položky:
- maximálne obmedzenie cukroviniek v potravinách;
- pravidelne jesť fermentované mliečne výrobky (kefír, jogurt), ktoré pomáhajú predchádzať dysbióze;
- je dôležité dodržiavať osobné hygienické opatrenia;
- odmietajú používať antibakteriálny gél a mydlo, pretože porušujú normálnu mikrobiálnu rovnováhu;
- Antibiotiká môžete užívať iba podľa pokynov lekára a nie podľa predpísaného postupu liečby.
video
Plesňové huby (mykóza): typy, vzhľad, fotografie, príznaky a liečba